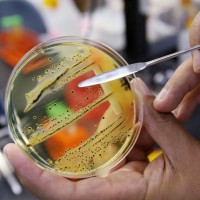

حرصت ريهانا على إطلالة مميزة خلال حضورها سباق جائزة الفورمولا 1 في لاس فيغاس، حيث لفتت الانتباه بوضع ساعة حول كاحلها من جاكوب آند كو، ثمنها 400 ألف دولار، مرصعة بأكثر من 70 قيراطاً من الماس المستدير والزمرد والذهب الأبيض عيار 18 قيراطاً.
وأكملت ريهانا الإطلالة بجاكيت جلد أسود من بالينسياغا وبنطلون ثمنه 4550 دولار.
وقالت الشركة المنتجة: “استعداداً لحدث الموضة، قررت ريهانا أن تضع ساعة بطريقة مختلفة تماماً”
وكانت ريهانا، واحدة من المشاهير، الذين حضروا الحدث، بينهم عارضة الأزياء والمغنية البريطانية كارا ديليفين، وعارضة الأزياء الألمانية والممثلة هايدي كلوم، وبراد بيت، وباريس هيلتون، وديفيد بيكهام.
وتستعد ريهانا لجولة غنائية ضخمة في 2024 و2025 بعد غياب أكثر من 5 أعوام عن الجولات الغنائية، كما تخطط لإصدار ألبومين، بعد أكثر من 6 أعوام.وكان آخر ظهور لها في سوبر بول 2023. وكالات
إيرلندا الشمالية تقطع أشجار مسلسل لعبة العروش الشهيرة
بدأ في أيرلندا الشمالية الإثنين الماضي ، قطع عدة أشجار اكتسبت شهرة بعد ظهورها في المسلسل التليفزيوني “لعبة العروش”.
وستقطع 6 أشجار في منطقة دارك هدجيز وتشذّب أشجار أخرى.
واكتسب “نفق الأشجار” في مقاطعة أنتريم بأيرلندا الشمالية شهرة بعد ظهوره في المسلسل التليفزيوني، وأصبح يجتذب أعداداً غفيرة من السائحين من مختلف أنحاء العالم.
غير أنه أثيرت مخاوف من حالة العديد من أشجار، الزان، اقتلعت عواصف بعضها في السنوات الأخيرة، حسب وكالة الأنباء البريطانية “بي.إيه ميديا”.
وبدأ قطع الأشجار بحضور بعض السائحين.
وقال ميرفين ستوري رئيس صندوق الحفاظ على منطقة دارك هدجيز إن قرار القطع جاء بعد صدور تقريرين عن ضرورة إزالة بعضها لدواعي السلامة.
واستطرد أن “ظهور هذه الأشجار لمدة ثماني ثوان في مسلسل لعبة العروش غير طريق بريجاج ومنطقة دارك هيدجز للأبد، وجاءنا اليوم رغم إغلاق الطريق أشخاص من كاليفورنيا”.
وأضاف “رغم أننا كنا نريد أن تبقى هذه الاشجار إلى الأبد، فالواقع أن ذلك لن يحدث، رغم أن بعضها يبلغ من العمر 300 عام، وبالتالي من الضروري إزالتها”.وكالات
البكتيريا المقاومة للمضادات الحيوية تهدد صحة الإنسان وغذاءه
تستخدم المضادات الحيوية في علاج العدوى الناتجة عن البكتيريا وبعض الفطريات. ويقلل تطور مقاومة المضادات الحيوية من الخيارات العلاجية الفعالة ضد عدوى ما، ويزيد صعوبة العلاج.
كما يزيد خطر تفشي الأمراض المعدية وصعوبة السيطرة عليها أو تكرار الإصابة بها بسهولة.
واعتبرت الكاتبة العامة للمجلس الوطني لهيئة الصيادلة ثريا النيفر أن البكتيريا المقاومة للمضادات الحيوية من أهم التهديدات الصحية والغذائية والاقتصادية للإنسان وزاد انتشارها حاليا بصفة ملحوظة، لافتة إلى أن الهيئة انخرطت مع مجموعة من الشركاء في إعداد مخطط عمل 2019 – 2023 للحد من انتشار البكتيريا المقاومة للمضادات الحيوية (توقف لمدة سنتين بسبب كوفيد – 19).
وأضافت النيفر في تصريح لوكالة تونس أفريقيا للأنباء أن منظمة الصحة العالمية حذرت في حال عدم إعداد مخطط عمل مناسب للحد من انتشار البكتيريا المقاومة للمضادات الحيوية على جميع المستويات فإن ذلك سيتسبب في 10 ملايين حالة وفاة كل سنة في غضون 2050.
استخدام المضادات الحيوية بجرعات غير فعالة أو لفترات أطول من اللازم يجعل من السهل على البكتيريا اكتساب المقاومة
استخدام المضادات الحيوية بجرعات غير فعالة أو لفترات أطول من اللازم يجعل من السهل على البكتيريا اكتساب المقاومة
ولفتت في هذا الصدد إلى أن منظمة الصحة العالمية أفادت بأن البكتيريا المقاومة للمضادات الحيوية تعتبر حاليا من التهديدات العشر الأولى لصحة الناس وغذائهم واقتصادهم ومن المتوقع أن تصبح السبب الأول في الوفاة قبل السرطان في المستقبل.
وأفادت بأن هيئة الصيادلة انخرطت مع كل من وزارة الصحة ووزارة الفلاحة والموارد المائية ومنظمة الغذاء والزراعة للأمم المتحدة والمنظمة الدولية لصحة الحيوان ومنظمة الصحة العالمية في إعداد مخطط عمل 2019 – 2023 للحد من انتشار البكتيريا المقاومة للمضادات الحيوية على جميع المستويات والذي حقق البعض من أهدافه رغم توقفه لمدة سنتين بسبب انتشار فايروس كورونا.
وأكدت أن المخطط نجح في تقليص مخاطر البكتيريا على المستوى البشري ويسعى إلى الحد من مخاطرها على مستوى الحيوانات التي تتم معالجتها بالمضادات الحيوية غير المراقبة والتي تباع بصفة عشوائية في الأسواق الشعبية ومجهولة المصدر حسب تقديرها، مبينة أن ذلك من شأنه أن يتسبب في انتقال المضادات الحيوية إلى الإنسان عبر الغذاء (اللحوم والألبان وغيرها).
ودعت الكاتبة العامة لهيئة الصيادلة إلى تفادي التطبيب الذاتي وإلى التحسيس والتوعية بالمخاطر المنجرة عنه وإلى توسيع التغطية الاجتماعية واتباع الإجراءات الوقائية، مشيرة في هذا الخصوص إلى وجود إطار تشريعي منظم لمسالك التوزيع.
وأفادت بأن هيئة الصيادلة برمجت تكوينا مستمرا لفائدة الصيادلة في غضون سنة 2024 حول موضوع البكتيريا المقاومة للمضادات الحيوية وترشيد استعمال المضادات الحيوية.
البكتيريا المقاومة للمضادات الحيوية من أهم التهديدات الصحية والغذائية والاقتصادية للإنسان وزاد انتشارها حاليا بصفة ملحوظة
يذكر أن المضادات الحيوية هي أدوية تستعمل للوقاية من عدوى الالتهابات البكتيرية وعلاجها، وتحدث مقاومة المضادات الحيوية عندما تغير البكتيريا نفسها استجابة لاستعمال تلك الأدوية وتبدي البكتيريا وليس الإنسان أو الحيوان مقاومة للمضادات الحيوية وقد تسبب للإنسان والحيوان عدوى التهابات يكون علاجها أصعب من تلك التي تسببها نظيرتها غير المقاومة للمضادات.
ويشير مصطلح مقاومة المضادات الحيوية إلى التغيير التكيفي أو الطفرة التي تحدث في بعض أنواع البكتيريا، والذي يسمح لها بالنمو والبقاء على قيد الحياة في ظل وجود المضادات الحيوية التي من شأنها في الأصل أن تكون قادرة على قتل أو إيقاف نمو البكتيريا المسببة للأمراض.وكالات
ترجمة المفاهيم الطبية تساعد في تجويد العملية التواصلية بين الطبيب والمريض
تتشكل العلاقة بين الطبيب والمريض عندما يلبي الطبيب الاحتياجات الطبية للمريض، وتحدث هذه العملية عادة في جو تسوده الموافقة. وتُبنى هذه العلاقة على الثقة والاحترام والتواصل والتفاهم المشترك بين الطبيب والمريض، شرط توفر لغة مفهومة بين الطرفين.
وأكد البروفيسور محمد البياز، أخصائي الطب التنفسي ومدير مركز طب النوم الجامعي بفاس، أن تدبير الحالة الصحية للمريض يتطلب، بالضرورة، عملية تواصلية سليمة لا يمكن أن تنجح دون لغة مفهومة من طرف الطبيب والمريض على حد سواء.
وأبرز الأخصائي، في حوار خص به وكالة المغرب العربي للأنباء، أن بعض المرضى يواجهون في علاقتهم مع الطبيب إشكالية تواصلية تتعلق بالوعاء اللغوي للمفاهيم الطبية المرتبطة بحالتهم الصحية، تتعمق كلما تدنى المستوى التعليمي لدى المريض مما يؤثر على نجاعة العلاج.
وسجل البياز، وهو مؤلف كتاب “المعجم الطبي المفهومي، أصالة وتجديد (عربي – فرنسي)” أنه رغم كون الطبيب والمريض مغربيين فإن لغة التدريس في كلية الطب، وهي اللغة الفرنسية، تصعب العملية التواصلية، فيضطر الطبيب إلى أن يقوم بدور المترجم دون أن يكون مكونا لذلك.
وأوضح أن الطبيب يجد نفسه مضطرا إلى ترجمة كلام المريض إلى اللغة الفرنسية بما يحتويه من معاناة وأعراض، لينتقل إلى ترجمة ثانية للمعلومات الطبية من الفرنسية إلى العامية المغربية، مبرزا أن هذه الترجمة والترجمة العكسية تتكرر خلال كل عملية تواصلية مما قد ينتج عنه أخطاء في فهم حديث المريض وفي تشخيص المرض، وبالتالي القرارات التي يتخذها الطبيب.
تدبير الحالة الصحية للمريض يتطلب عملية تواصلية سليمة لا يمكن أن تنجح دون لغة مفهومة من طرف الطبيب والمريض
وتابع أستاذ التعليم العالي بكلية الطب بفاس أن الطبيب قد يواجه صعوبات في إيجاد المصطلحات المناسبة للتواصل والتحدث بلغة تمزج بين الفرنسية والعامية المغربية، ما يعطي الانطباع، أحيانا، لدى المريض بأن الطبيب لم يفهم معاناته، ويضعف بذلك ثقته في مؤهلاته.
وتتجلى مخاطر اختلال العملية التواصلية، بحسب البروفيسور البياز، في كونها تؤثر في كل مراحل تدبير المرض، بدءا من التشخيص الذي يتطلب فهما سريريا واضحا واختبارات تكميلية ملائمة، وانتهاء بالعلاج وتقييم نتائجه.
وحول ما إذا كانت بنية اللغة العربية تسعف لتدريس العلوم الطبية، أوضح أن هذه اللغة تتوفر على مخزون لغوي ومصطلحي يفوق أغلب لغات العالم، ومن بينها اللغتان الإنجليزية والفرنسية، عازيا ذلك إلى عدة مزايا، منها الرصيد المتراكم تاريخيا في المعاجم والكتب اللغوية والعلمية التراثية إبان أوج الحضارة الإسلامية، وقدرة البنية الاشتقاقية للعربية، من خلال الأوزان الصرفية ودلالاتها، على توليد مختلف المصطلحات انطلاقا من المفاهيم العلمية الحديثة ومسايرة ما استجد منها، فضلا عن الإمكانيات التي تتيحها آليات أخرى كالنحت والاستعارة والتعريب والتبسيط.
وشدد أستاذ التعليم العالي على أن تدريس الطب باللغة العربية، لا يتعلق فقط بترجمة المصطلحات العلمية الأجنبية، ولكن أيضا بترجمة المفاهيم التي تحملها، وتداولها في النص الطبي التلقيني للطالب والنص التربوي والتحسيسي للمريض، حتى لا تتحول الترجمة العربية لمصطلحات العلوم الكونية، ومن بينها العلوم الصحية، إلى مجرد ترف فكري ومجال لنقاش عقيم لا يفضي إلا إلى فوضى مصطلحية.
مخاطر اختلال العملية التواصلية تتجلى في كونها تؤثر في كل مراحل تدبير المرض، بدءا من التشخيص وانتهاءا بالعلاج وتقييم نتائجه
ولفت البروفيسور البياز إلى أن “المشكلة لا تكمن في توحيد المصطلحات، وإن كان ذلك ضروريا، ولكن في عدم تداولها مما يجعلها لا تتركز في الأذهان، لتصبح عرضة للتغيير وتعدد الترجمات باستعمال فوضوي سواء في وسائل الإعلام أو برامج التكوين المحدود”، مؤكدا على ضرورة وجود مشروع عربي موحد لتدريس العلوم الكونية باللغة العربية، يضمن تداول المصطلحات وتركيزها وتعميمها بما يعيد للغة العربية مكانتها في المشاريع التنموية.
وفي هذا الصدد، سجل أن الهدف الأساسي من تأليفه لكتاب “المعجم الطبي المفهومي، أصالة وتجديد (عربي – فرنسي)”، يتمثل في تلبية حاجيات المستعمل (الأستاذ والطالب) في مجال تدريس العلوم الصحية وتسهيل التواصل مع المريض وتحسيس عموم المواطنين، وذلك بالاعتماد على منهجية واضحة لتوليد مصطلحات تتميز بمعايير الدلالة العلمية والاختصار وسهولة التداول والمرونة الصرفية، قابلة للتعميم على مختلف العلوم الكونية، وقادرة على مسايرة ما يستجد فيها.
ولمعالجة مشكلة تعدد المنهجيات في توليد المصطلح، اقترح المؤلف منهجية موحدة تمزج بين الأصالة والتجديد وتوظف كل آليات اللغة العربية، وهي منهجية الترجمة المفهومية، معربا عن أمله في أن يكون المعجم الطبي المفهومي نقطة انطلاق نحو معاجم علمية متخصصة أخرى، وإصدار نماذج تطبيقية تلتزم بهذه المنهجية من خلال تحيين مقررات الطب التي سبق أن أشرف على ترجمتها، واستكمال ترجمة مقررات أخرى في مجال تدريس الطب.وكالات
اكتشاف أحياء سكنية تعود إلى 5 آلاف عام جنوب العراق
أُعلن في العراق عن اكتشاف أحياء سكنية تعود إلى أكثر من خمسة آلاف عام.
واكتشفت البعثة الأميركية العاملة في محافظة ذي قار العديد من الحارات السكنية التي تعود إلى عصر فجر السلالات.
كما اكتشفت تكوينا بنائيا يقارب في تصميمه مطعما شعبيا، حيث وجدت بقايا مواقد وأفران كانت تستخدم في إعداد الطعام وإنضاج الخبز كما انتشرت المصطبات الملاصقة للجدران المعدة للجلوس وتناول الطعام عليها.
جدير بالذكر أن عصر فجر السلالات هو من عصور بلاد ما بين النهرين القديمة بدأ حوالي سنة 2800 ق.م واستمر لمدة ستة قرون، ويعرف بالعصر السومري القديم أو باسم “السلالة الحاكمة”.وكالات
مريضة تستعيد النطق بفضل زرع حنجرة للمرة الأولى في فرنسا
استفادت امرأة أخيراً من أول عملية زرع حنجرة في فرنسا، في تدخل جراحي قُدم، الاثنين الماضي ، في ليون (وسط شرق) من جانب فريق طبي يأمل أن يتمكن قريباً من تكرار هذا «الإنجاز» النادر على المستوى العالمي.
وكانت المريضة كارين (49 عاماً)، التي عُرّف عنها فقط من خلال اسمها الأول، تتنفس من خلال ثقب القصبة الهوائية منذ 20 عاماً تقريباً، من دون أن تكون قادرة على التحدث، بسبب مضاعفات مرتبطة بالتنبيب بعد سكتة قلبية تعرّضت لها في عام 1996.
وبعد أيام قليلة من عملية الزرع التي أجريت يومي 2 و 3 سبتمبر في ليون، تمكنت كارين من قول بضع كلمات. ومنذ ذلك الحين، تابعت جلسات إعادة تأهيل للأحبال الصوتية والبلع والتنفس مع معالِجة للنطق، على أمل استعادة القدرة على الكلام بشكل دائم. وقد عُزّز علاجها المثبط للمناعة بعد بداية رفض للعضو المزروع، لكنها تمكنت من العودة إلى منزلها في جنوب فرنسا في 26 أكتوبر .
لذلك، لم يكن ممكناً أن تشارك في المؤتمر الخاص بتقديم العملية، لكنها أوضحت كتابياً أنها تطوعت قبل 10 سنوات للمشاركة في هذه التجربة العلمية «للعودة إلى الحياة الطبيعية». وكتبت: «لم تسمعني بناتي أتكلم قط»، مؤكدة أنها مسلحة بـ«الشجاعة» و«الصبر» لمواجهة الألم والمضيّ قدماً في مسار إعادة التعلّم.
كما أبدى البروفسور فيليب سيروز، رئيس قسم الأنف والأذن والحنجرة وجراحة الرأس والرقبة في مستشفى كروا روس، إصراراً قبل تنسيق عملية الزرع غير المسبوقة هذه في فرنسا.
نشأت فكرة هذا التدخل الجراحي إثر أول عملية زرع حنجرة في العالم، أجريت عام 1998 في كليفلاند بالولايات المتحدة، لرجل فقد أحباله الصوتية في حادث دراجة نارية.
وقد استفسر الجراح عن الأمر، لكنه لم يذهب بعيداً في ذلك، وصولاً إلى عام 2010 عندما التقى «عن طريق الصدفة قليلاً» خلال أحد المؤتمرات زميلاً كولومبياً أعاد إجراء هذه العملية من دون أن ينشر أي معلومات عنها.
وقد دعاه الطبيب لويس فرناندو تينتيناغو لوندونو إلى مدينة كالي الكولومبية لمدة أسبوع ليعلّمه كيفية سحب الحنجرة، «وهي من أكثر الجوانب تعقيداً» لأن هذا العضو «يضم أعصاباً صغيرة جداً، ومُزود بأوعية دموية بواسطة شرايين وأوردة متقاطعة صغيرة جداً»، وفق البروفسور سيروز.
وعلى مدى العقد التالي، تدرب مع فريق من الخبراء، وحصل على الموافقات، وبدأ بالبحث عن المرضى المؤهلين. وفي عام 2019 تعرف على «كارين». لكن جائحة «كوفيد» أوقفت كل شيء.
في هذه الأثناء، لاحظت السجلات الطبية في العالم عمليتين لزرع الحنجرة، واحدة في كاليفورنيا في عام 2010 وأخرى في بولندا في عام 2015. وهذا العدد ليس كبيراً؛ لأن هذه العمليات لا تعطى أي أولوية؛ فاختلال الحنجرة يؤدي إلى إعاقة شديدة، لكنه لا يشكل خطراً على حياة المرضى.
في عام 2022، عاد الفريق الطبي الفرنسي لإكمال ما بدأه في هذا المجال. وبقي أمامه العثور على واهبة مناسبة، ما يتطلب بالنسبة للحنجرة «خصائص تشريحية متوافقة تماماً مع المتلقية، من حيث الجنس والوزن والطول وفصيلة الدم”وكالات
طبيبة تكشف العواقب الخطيرة لاستخدام الشموع المعطرة في المنزل
يمكن أن تسبب المنتجات العطرية مثل البخاخات والبخور والشموع مشكلات صحية، لأنها قد تحتوي على مواد عضوية متطايرة خطرة، مثل الفثالات والبنزول والفورمالدهيد وغيرها.
وتشير الدكتورة الكسندرا فيلييفا، إلى أنه عند تلامس هذه المواد مع الغشاء المخاطي للجهاز التنفسي، يسبب تهيجا ويمكن أن يؤدي أيضا إلى تفاقم أعراض الربو وأمراض الجهاز التنفسي الأخرى. وبالتالي، فإن بعض المركبات، مثل الفورمالدهيد والبنزول، تكون سامة ويمكن أن تتراكم في الجسم، ما يسبب تلف الخلايا وحصول طفرات.
ووفقا لها، استخدام هذه المواد المعطرة لفترة طويلة يزيد من خطر الإصابة بالأمراض المزمنة بما فيها السرطان. لأن الفثالات يمكن أن تعطل عمل منظومة الغدد الصماء، ما يؤدي إلى اضطرابات هرمونية، ويمكن أن يكون لمكوناتها تأثير سلبي على الجهاز العصبي المركزي: ما يسبب الصداع والتعب وقلة النوم وضعف الإدراك. كما تضاف الزيوت العطرية التي تتكون من العديد من المكونات الكيميائية إلى الشموع.
وتشير الطبيبة إلى أن أخطر المكونات هو ثنائي إيثيل الفثالات (Diethyl phthalate) – الذي يستخدم لتركيز رائحة العطر. هذه المادة الكيميائية يمكن أن تسبب مشكلات تتعلق بالوظيفة الإنجابية. لذلك فإن الشموع الأكثر أمانا للصحة هي تلك المصنوعة من فول الصويا أو شمع العسل مع إضافة الزيوت الأساسية. كما أنه حتى المنتجات التي تتكون بالكامل من مكونات طبيعية، مثل البخور، يمكن أن تكون خطيرة لأنه في أثناء احتراقها يمكن أن تتكون مركبات كيميائية ضارة بالصحة. وتوصي الطبيبة باستخدامها لفترات قصيرة وفي أماكن ذات تهوية جيدة.وكالات
دخلت موسوعة غينيس بصنع أطول شعر مستعار في العالم
دخلت النيجيرية هيلين ويليامز موسوعة غينيس للأرقام القياسية، بعد أن تمكنت من صنع أطول شعر مستعار في العالم.
بلغ طول الشعر المستعار الذي صنعته ويليامز 350 مترا، واستغرق صنعه 11 يوما، واستخدم لصناعته ألف خصلة شعر خاصة، و12 علبة مثبت شعر، و6.3 ألف دبوس شعر، و35 أنبوبا من الغراء اللاصق.
ووفقا لموقع غينيس للأرقام القياسية فإن صاحبة هذا الإنجاز تعمل كصانعة للشعر المستعار منذ 8 سنوات، وتصنع ما بين 50 إلى 300 باروكة أسبوعيا، وتنقل خبراتها لطلابها الذين تعلمهم هذه المهنة.
وفي تعليق على هذا العمل قالت هيلين ويليامز:” هذا أفضل إنجاز تمكنت من تحقيقه في حياتي”.وكالات
خبراء: العطش المفرط يشير إلى أعراض مرضية
من المعروف أن الشعور بالعطش هو حاجة إنسانية طبيعية تعكس الحاجة الفيسويولوجية للجسم، ولكن في بعض الأحيان يمكن أن يكون العطش المفرط دليلاً على وجود أعراض مرضية.
يقول الخبراء، إن العطش المفرط قد يدل على ارتفاع نسبة السكر في الدم، في مرحلة ما قبل الإصابة بمرض السكري، فعندما ترتفع مستويات السكر في الدم في مرحلة ما قبل السكري، يحاول الجسم التخلص من السكر الزائد عن طريق طرحه في البول، وهذه العملية تسبب فقدان الماء، ونتيجة لهذه الخسارة، يعاني المريض من جفاف خفيف ويشعر بالعطش.
ويقول الدكتور آنو جايكواد، استشاري أمراض السكري وطب الشيخوخة في مستشفى DPU الخاص التخصصي الفائق في بيون: “يُشار إلى المريض الذي يعاني من ارتفاع نسبة السكر في الدم، ولا يستوفي معايير مرض السكري، على أنه مصاب بمقدمات مرض السكري، وعندما ترتفع مستويات السكر في الدم في مرحلة ما قبل السكري، يحاول الجسم التخلص من السكر الزائد عن طريق طرحه في البول، وفي هذه العملية يتم فقدان الماء.”
يمكن أن تشمل أعراض مرحلة ما قبل السكري، على سبيل المثال لا الحصر، العطش الشديد، أو كثرة التبول، أو عدم وضوح الرؤية. إذا لم يتم علاج مقدمات السكري، فيمكن أن يتطور إلى مرض السكري من النوع 2، ويسبب مشاكل في الكلى والأوعية الدموية والعينين والأعصاب.
وقد يكون لدى المريض أيضاً عطش مستمر، وشعور بالجفاف المستمر، الذي لا يزول بغض النظر عن كمية الماء التي يستهلكها، لذلك فإن التبول المنتظم والعطش المستمر قد يسببان اضطرابات في جدول النوم والروتين اليومي، بحسب صحيفة تايمز أوف إنديا.وكالات
بسبب نقص الممرضات.. مستشفيات في أمريكا تلجأ إلى التطبيقات
في ظل النقص في الولايات المتحدة في أعداد الممرضات، تلجأ مستشفيات أمريكية إلى تطبيقات للااستعانة بخدمات صحية محدّدة توفّرها هؤلاء المتخصصات اللواتي يتلقّين لقاء ذلك أجوراً أفضل مما لو كن يعملن بعقود تقليدية، فضلاً عن مرونة أكبر في أوقاتهن.
ويتزايد اعتماد المستشفيات الأمريكية على صيغة العمل هذه التي تُعد مربحة أكثر للممرضات وتتسم بمرونة أكبر في أوقاتهنّ، في خطوة تحاول هذه المؤسسات بها إيجاد أساليب عمل جديدة لتعويض النقص في موظّفيها.
ودفعت الجائحة نحو مئة ألف ممرضة لترك وظائفهنّ بسبب ضغوط الأزمة الصحية، حسب تقرير حديث لمجلسهنّ الوطني.
وتعتزم أكثر من 610 آلاف ممرضة ترك المهنة بحلول 2027 إما بسبب التعب الكبير أو لأنّهنّ سيتقاعدن.
ويُعدّ هذا الرقم مرتفعاً مقارنة مع 5.2 ملايين ممرضة وممرض كانوا يمارسون المهنة في 2022.
تؤكد ديبورا فيسكوني، الرئيسة التنفيذية لمركز بيرغن نيو بريدج الطبي، أنّ ثمة “أزمة توظيف في النظام الصحي”.
وتشير إلى أن “عدداً كبيراً من العاملين في هذا المجال قرروا التقاعد مبكراً أو ترك المهنة”.
ومنذ أن بدأ المستشفى يتعامل مع منصة “كير ريف”، سجل 150متخصصاً أسماءهم للعمل فيه.
وتقول فيسكوني: “يمكننا إيجاد قادر على أن يداوم ساعات قليلة”، مضيفة أنّ “80% من الاحتياجات سُدّت بهذه الطريقة”.
وشهدت منصة “أيا هيلث كير” زيادةً في مناوبات الممرضات اللواتي يعملن بهذا النموذج 54% في 2022. وعلى المستوى الوطني، ارتفع عدد المناوبات المقترحة عبر المنصة بـ62%، حسب نائبة الرئيسة صوفيا موريس.
ويستفيد آخرون، على غرار شانتال تشامبرز، من المرونة الموفرة لهم عندما يختارون بأنفسهم دواماتهم.
وخلال إقامتها في سان دييغو، سجلت تشامبرز في منصة “أيا هيلث كير”، مستفيدةً من الخيارات المُتاحة لها لتوفّق بين انشغالاتها العائلية وعملها، لقضاء مزيد من الوقت مع ابنيها.
أما ديبورا فيسكوني، فتعتبر أن استخدام المنصات سيزداد، في وقت ينظر الموظفون إلى عملهم بشكل مختلف ويسعون إما للحصول على مزيد من وقت الفراغ أو العمل بصورة أكبر، استناداً إلى احتياجات كلّ منهم.
وتقول رئيسة الممرضات في “كير ريف” سوزان باسلي: “لدينا نسبة عالية من الشيخوخة بين السكان، ما يتطلب مزيداً من الرعاية الصحية، ونحن على شفير أزمة”، ما يدفع المستشفيات إلى “النظر في خيارات أكثر مرونة” من صيغة العمل التقليدية.
لكن البعض يبدي قلقاً من نتائج قد تنعكس سلباً على رعاية المرضى. تشير ميشيل ماهون، من نقابة الممرضات، إلى أن “الخطر يكمن في رؤية مستشفيات غير مُعدَّة بشكل جيد، وغياب عدد كاف من الموظفين للتعامل مع الطوارئ أو العدد الكبير من المرضى”.
وتلفت إلى خطر آخر يتمثل في الجهل بالأمور اللوجيستية في العمل، مثل معرفة مكان تخزين معدات الطوارئ مثلاً.
وتؤكد سارة ديوايلد أن هذه مشكلة تحمل أهمية كبيرة. وتتولى الممرضة المتحدرة من ولاية ميسوري تدريب الممرضات على صيغة “غيغ وورك” في المستشفى الذي تعمل فيه، مع عجزها عن تقييم مهاراتهنّ كما يجب، على ما تؤكد.
وتقول: “لم يعد لدي الوقت الكافي لتوفير رعاية لمرضاي لأني أساعد الممرضات ليتعلّمن رعاية لمرضاهنّ”، مضيفةً “بدأت أشعر بالإرهاق”.
وبما أنّ الممرضات العاملات بنموذج “غيغ وورك” يتقاضين مبالغ قد تتخطى ضعف” ما يتقاضاه آخرون، “قد يحدث هذا الأمر توترا”.
لكن ديبورا فيسكوني تبدي تفاؤلها، وتتوقع أن يتحسّن الوضع لأن هؤلاء الممرضات يملن إلى العودة إلى المستشفيات نفسها.وكالات
أعمال أمازون ونتفليكس تتصدر جوائز إيمي الدولية الـ51
تصدّرت الإنتاجات التلفزيونية الخاصة بمنصتي أمازون ونتفليكس للبث الخاص تكريمات الدورة الـ51 من “جوائز إيمي الدولية”، التي أقيمت في نيويورك.
تربعت على قمة الأعمال الفائزة مسلسلات من حول العالم، بدءاً من “القضاء Yargi” التركي، “الإمبراطورة The Empress” الألماني، والدراما المكسيكية “السقوط La Caída”، كما تم تكريم اثنين من عباقرة صناعة الدراما حول العالم.
ضمّت الترشيحات مسلسلات وبرامج تلفزيونية متنوعة، حيث فاز مسلسل “الجسر A Ponte” البرازيلي بجائزة أفضل المسلسلات المرتجلة “سيت كوم”، وتقاسم مسلسلان من إنتاج نتفليكس، أحدهما من الهند والآخر من بريطانيا جائزة أفضل عمل كوميدي.
أما مسلسل “القضاء” التركي، فنال جائزة أفضل عمل غير ناطق بالإنجليزية، بسبب حبكته القانونية، بينما نالت الدراما الألمانية “الأمبراطورة”، من إنتاج نتفليكس، جائزة أفضل أزياء وديكور، انطلاقاً من أحداثها التي تجري في البلاط الملكي بفيينا خلال القرن التاسع عشر.
بدوره، مسلسل “السقوط” الذي أنتجته أمازون، فنالت بطلته المكسيكية كارلا سوزا جائزة أفضل ممثلة، في حين تُوّج الممثل الإنجليزي مارتن فريمان عن دوره في سلسلة “المستجيب الأوّل The Responder”، من إنتاج نتفليكس، بجائزة أفضل ممثل.
حصل برنامج “Buffy Sainte-Marie: Carry It On” الكندي على جائزة البرامج الفنية، رغم تعرض بطلته الرئيسية لفضيحة تعود إلى نسبها وعرقها، وتسريب معلومات حول إمكانية بيعها، حين كانت طفلة إلى أسرة من عرق آخر.
ومن الفن إلى الوثائقي الإنساني، حاز الوثائقي “ماريوبول: حكايا الناس” الأوكراني جائزة أفضل فيلم يوثق تحول مدينة ماريوبول الأوكرانية من العيش في مدينة مزدهرة إلى أنقاض مزقتها الحرب، متشاركين قصصاً صادمة عن الشجاعة والخسارة والتصميم على الحياة رغم اندلاع الحرب في أوكرانيا.
فيما قدّم الحفل الممثل الكوميدي النيوزيلندي ريس داربي، مُنح المنتج التنفيذي لفيلم لمسلسل “الخلافة Succession” (نتفليكس) جيسي أرمسترونغ “جائزة مؤسسين إيمي الأوائل” تقديراً لجهوده في إعلاء شأن الدراما حول العالم.
أما المؤسس المشارك في شبكة “بالاجي تيلي فيلمز” الهندي إكتار كابور فحصل على جائزة لجنة التحكيم الخاصة، لدوره في تطوير صناعة بلاده والسعي لنقلها إلى العالمية.وكالات